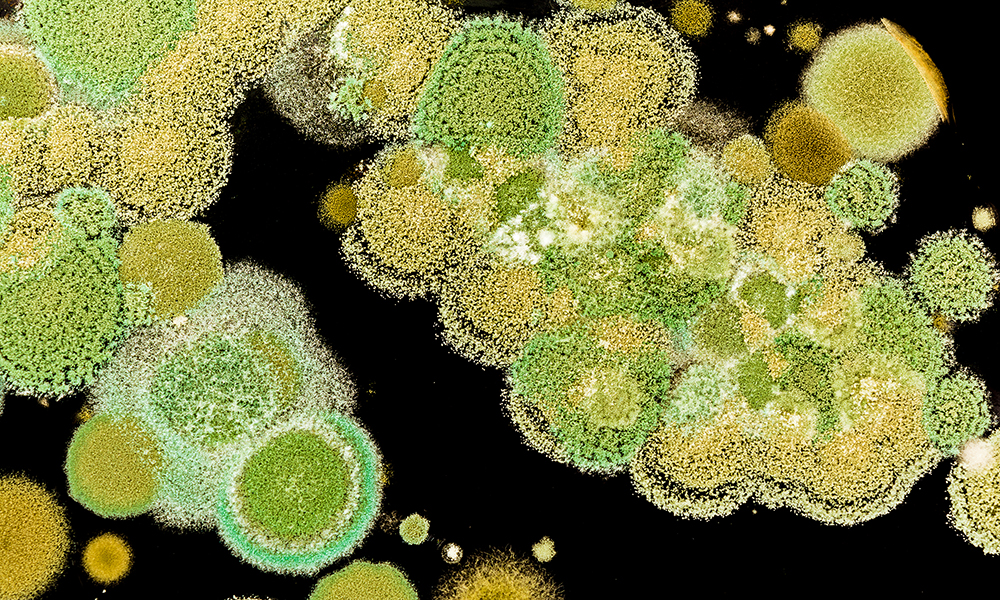

Tecnologie assistive: strumenti per l’inclusione
In un’epoca in cui lo smartphone sembra essere diventato un’estensione naturale del nostro braccio, spesso dimentichiamo che la tecnologia non serve solo a semplificare
Dai campi alla tavola, gli italiani continuano a sprecare cibo. Un aiuto arriva dalla ricerca tecnologica e dalle App che possono cambiare le abitudini quotidiane per diminuire lo spreco alimentare.
Mettete da parte 4 euro e 91 centesimi a settimana, poi buttateli nel cestino della spazzatura. Se vi sembra un’azione senza senso, sappiate che è quello che le nostre famiglie fanno quotidianamente a causa dello spreco di cibo. Il dato è stato diffuso in occasione della 7^ Giornata Nazionale di Prevenzione dello spreco alimentare dall’Osservatorio Waste Watcher di Last Minute Market. La cifra annua dello spreco in Italia, secondo la ricerca, raggiunge i 6,5 miliardi di Euro e con il dato della filiera produzione/distribuzione si raggiunge una cifra di poco inferiore ai 10 miliardi di euro, per un valore complessivo che sfiora i 12 miliardi ogni anno, lo 0,8% del nostro PIL.
Tuttavia, la ricerca di quest’anno ha regalato anche una preziosissima buona notizia: per la prima volta in 10 anni gli italiani hanno invertito la tendenza e per il 2020 si prevede il 25 per cento in meno di spreco alimentare rispetto l’anno scorso. «La situazione è in miglioramento – ha dichiarato a Changes il professore Andrea Segrè, fondatore di Last Minute Market e della campagna Spreco Zero e coordinatore del Piano Nazionale di Prevenzione dello Spreco Alimentare –. La percezione dello spreco delle famiglie italiane, infatti, è in calo del 20% rispetto agli anni scorsi: le campagne di sensibilizzazione evidentemente stanno funzionando».
Nell’indagine Waste Watcher il 26% degli intervistati ha dichiarato di aver “decisamente” aumentato (26%) o semplicemente aumentato (42%) l’attenzione verso il problema dello spreco di cibo. Tra i cibi più sperperati primeggiano frutta, verdura, latte e formaggi. Spesso a essere sprecato è il cibo acquistato in grande quantità per approfittare di offerte speciale (24%). «Molte campagne di marketing (pensiamo al 3×2, NdR) non aiutano a contenere lo spreco – osserva sempre il professore Segrè – Continuiamo a sciupare troppo cibo tra le mura domestiche, anche perché nella filiera si sta lavorando molto per rendere più efficiente e sostenibile sia la distribuzione che la produzione di beni».
Algoritmi di intelligenza artificiale sono infatti sempre più applicati per eseguire previsioni sulla scadenza dei cibi, in modo da razionalizzare le scorte, cercando di stabilire con sempre più precisione gli stock necessari per la vendita, evitando perciò un surplus di acquisti e di cibo invenduto. Secondo la FAO un terzo di tutti i prodotti alimentari a livello mondiale (1,3 miliardi di tonnellate) viene perduto o sprecato ogni anno lungo l’intera catena di approvvigionamento: circa 685 miliardi di euro.
Per contenere il fenomeno, nel settore food & beverage, la cossiddetta logistica 4.0 utilizza sensori ed elabora dati al fine di monitorare gli itinerari percorsi da alimenti e bevande, prevedendo le condizioni con cui i cibi arrivano al destinatario. Nel settore primario, da qualche anno si parla sempre più spesso di agricoltura 4.0, trainata dall’uso della robotica, dell’intelligenza artificiale, dei droni e della data analysis. Secondo l’Osservatorio Smart Agrifood del Politecnico di Milano il mercato italiano dell’agricoltura 4.0 nel 2018 ha registrato un valore fra i 370 e i 430 milioni di euro. Si tratta di un mercato in cui sono presenti oltre 110 aziende fornitrici, tra cui diverse start-up che hanno lanciato oltre 300 soluzioni hi-tech, utilizzate dal 55% delle aziende agricole per ottimizzare la produzione e contenere gli sprechi idrici o di prodotto finale.
L’Istituto Italiano di Tecnologia di Genova sta studiando un nuovo tipo di materiale: i cristalli fotonici, in grado di cambiare colore in maniera tempestiva nel momento iniziale del processo di contaminazione batterica dell’alimento. I cristalli segnalano il cibo contaminato (per esempio con il noto batterio Escherichia Coli), in modo che il consumatore possa facilmente capire quale cibo buttare e quale conservare ancora nel frigorifero.
Sempre sul deperimento degli alimenti punta la start-up israeliana chiamata Wasteless che ha sviluppato un algoritmo di prezzi dinamici che variano in base alla data di scadenza dell’alimento: in questo modo il consumatore sarà invogliato a comprare il cibo di prossima scadenza, in quanto di minor costo.
Sul cambiamento delle abitudini del consumatore, infine, insiste tutto il mondo della app economy: Too Good To Go si basa sulla cosiddetta “Magic Box”, che gli esercenti mettono a disposizione a poco prezzo e che i consumatori prenotano direttamente dal loro smartphone. Pane, pizza, ma anche frutta, verdura e altri beni, altrimenti invenduti, sono messi da parte e consegnati al cliente, che passa a prenderli direttamente in negozio. «Siamo arrivati in Italia nel 2019 e i risultati ci stanno premiando – ci ha raccontato il country manager Italia di Too Good To Go Eugenio Sapora –. Nella penisola contiamo 750.000 utenti registrati, più di 350.000 Magic Box vendute e oltre tremila negozi coinvolti».
Accanto a Too Good To Go sta crescendo un vero e proprio mondo di app e progetti 2.0, che sfruttano i social per creare community e combattere lo spreco di cibo. È il caso di “Avanzi Popolo“, che invita a scambiare il cibo in scadenza con i propri vicini. L’app Bring The Food aiuta, invece, gli esercenti a donare cibo in beneficienza, mentre My Foody, su segnalazione dei supermercati, mette a disposizione degli iscritti i prodotti vicini alla scadenza.
Punto di svolta nel settore in Italia è stata la Legge Gadda del 2016, che ha puntato a liberare da lacci e lacciuoli burocratici gli esercenti, che possono donare o scontare beni a rischio-spreco con più facilità. Tra reale e virtuale, dunque, la strada intrapresa sembrerebbe quella giusta. La partita però è ancora molto lunga e non può prescindere da quella che il Prof. Andrea Segre immagina come “una nuova educazione civica basata sulla lotta allo spreco alimentare“. L’impegno non è rinviabile, in gioco c’è molto più di 4,91 euro a settimana.